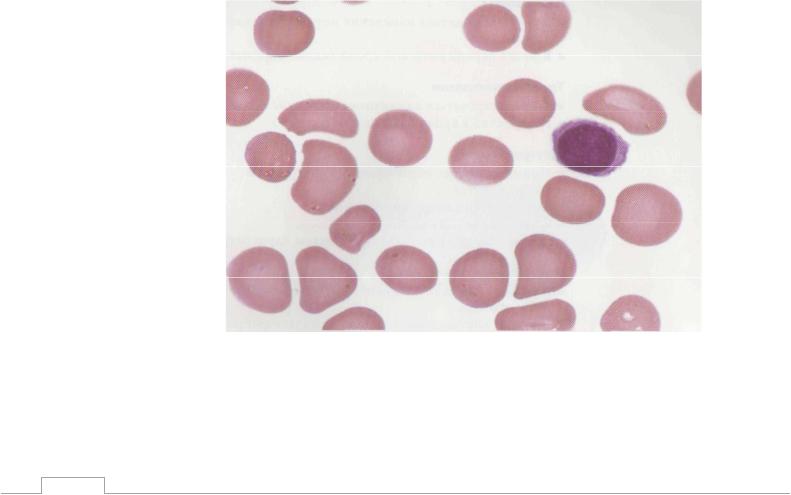

Материал: blood4

Контрольные задания к разделу III.2
1. Внутриклеточный гемолиз характерен для: А) Наследственного сфероцитоза Б) Болезни Маркиафавы-Микелли В) Болезни Жильбера
2.Гемотрансфузии у больных аутоиммунной гемолитической анемией: А) Безопасны Б) Часто приводят к разрушению эритроцитов
В) Трудны, так как трудно типировать эритроциты реципиента Г) Реакции можно избежать, если гемотрансфузии проводить очень медленно
Д) Реакции можно избежать, если гемотрансфузии проводить очень быстро
3.К гемолитическим анемиям относятся: А) Талассемия Б) Болезнь Маркиафавы-Микелли
В) Сидеробластная анемия Г) Железодефицитная анемия
4.Аутоиммунная гемолитическая анемия характерна для: А) Инфекционного мононуклеоза Б) Хронического лимфолейкоза В) Системной красной волчанки Г) Лечения пенициллином Д) Лимфом
5.Увеличение селезенки у больных аутоиммунной гемолитической анемией: А) Не возникает никогда Б) Возникает при тепловой аутоиммунной гемолитической анемии
В) Всегда сочетается с увеличением печени Г) Обязательный признак
Д) Возникает при холодовой агглютининовой болезни
6.Прямая проба Кумбса:
А) Применяется антиглобулиновая сыворотка, полученная путем иммунизации кроликов Б) При присоединении сыворотки возникает агглютинация эритроцитов больного
В) При присоединении сыворотки возникает агглютинация эритроцитов донора Г) Применяется для диагностики аутоиммунной гемолитической анемии
7. Умеренное повышение уровня билирубина характерно для: А) Железодефицитной анемии Б) Аутоиммунной гемолитической анемии острого течения В) В-12 дефицитной анемии
Г) Наследственного сфероцитоза в период криза Д) Болезни Маркиафавы-Микелли
55

8. Сфероцитоз эритроцитов:
А) Встречается только при болезни Минковского-Шоффара Б) Характерен для В-12 дефицитной анемии
В) Встречается при тепловой аутоиммунной гемолитической анемии Г) Признак внутрисосудистого гемолиза
9.После спленэктомии при наследственном сфероцитозе: А) В крови не определяются сфероциты Б) Прекращается разрушение эритроцитов В) Возникает тромбоцитоз Г) Возникает тромбоцитопения
10.У больного имеется анемия, повышение уровня непрямого билирубина и увеличение селезенки. Вы можете предположить:
А) Наследственный сфероцитоз Б) Талассемию В) В-12 дефицитную анемию
Г) Болезнь Маркиафавы-Микели
11.Внутрисосудистый гемолиз:
А) Характерен для большинства гемолитических анемий Б) Характеризуется повышением уровня непрямого билирубина
В) Характеризуется повышением уровня прямого билирубина Г) Характеризуется повышением уровня свободного гемоглобина Д) Характерна гемоглобинурия
12.Анурия и почечная недостаточность при гемолитической анемии: А) Не возникает никогда Б) Возникает всегда
В) Характерна для внутриклеточного гемолиза Г) Характерна для внутрисосудистого гемолиза
13.Что из перечисленного верно в отношении диагностики аутоиммунной гемолитической анемии:
А) Отрицательная прямая проба Кумбса не исключает диагноза Б) Агрегат-гемагглютинационная проба более информативна
В) Положительнаяагрегат-гемагглютинационная проба обязательный признак
14.Если у больного появляется черная моча, то можно думать о:
А) Анемии Маркиафавы - Микели
Б) Аутоиммунной анемии с холодовыми антителами класса IgG В) Маршевой гемоглобинурии Г) Наследственном сфероцитозе
15. Для какого заболевания характерен внутрисосудистый гемолиз: А) Наследственный сфероцитоз Б) Талассемия
В) Тепловая аутоиммунная гемолитическая анемия Г) Болезнь Маркиафавы-Микели
56

16. Клиническая задача.
Больная Д., 25 лет, поступила в стационар с жалобами на общую слабость,быструю утомляемость, головокружение, частые головные боли, периодически приступообразные боли в правом подреберье. Из анамнеза выяснено, что плохое самочувствие беспокоит ее с юношеских лет, особенно ухудшалось после простуды, когда долго не могла восстановить работоспособность, в эти же периоды окружающие обращали внимание на желтушность кожи и склер пациентки. Мать здорова, у отца «больна печень – желтуха, низкий гемоглобин», сестер и братьев нет.
Объективно: Общее состояние больной средней тяжести. Кожные покровы и слизистые бледно-желтушные. Высокое небо, удлиненный череп. Лимфатические узлы не увеличены. ЧД – 18 в минуту. Дыхание везикулярное. Пульс ритмичный с частотой 96 уд/мин., удовлетворительного наполнения и напряжения. АД – 90/60 мм. рт. ст. Тоны сердца звучные, определяется небольшой систолический шум на верхушке. Живот мягкий, безболезненный. Печень пальпируются на 4-5 см ниже реберной дуги, плотная, слегка болезненная, определяется также выраженная болезненность в зоне проекции желчного пузыря. Селезенка пальпируется на 12 - 14 см ниже реберной дуги, немного болезненная, плотная. Отеков нет.
Анализ крови общий.
Эритроциты – 2,4 *1012/л, гемоглобин – 80 г/л, цветовой показатель – 1,0, ретикулоциты –15‰. Тромбоциты – 150,0 *109/л. Лейкоциты – 9,8 *109/л,
сегментоядерные - 67%, лимфоциты – 26%, моноциты – 7%. СОЭ – 30 мм/ч. Анизоцитоз ++; пойкилоцитоз +; микросфероцитоз +++.
Анализ крови биохимический.
Креатинин – 95 мкмоль/л. Общий белок – 65 г/л. Билирубин прямой – 2,0 мкмоль/л, непрямой – 45,0 мкмоль/л, АСТ – 0,20 ммоль/л, АЛТ – 0,3 ммоль/л, Щелочная фосфатаза – 125 ед/л, Сахар крови – 4,5 ммоль/л.
Прямая проба Кумбса – отрицательная.
Вопросы:
1. Сформулируйте предварительный диагноз?
2.С какими заболеваниями необходимо провести дифференциальную диагностику?
3.Дайте характеристику изменений в гемограмме?
4.Определите методы дополнительного обследования?
5.Для чего выполняется проба на осмотическую стойкость эритроцитов?
6.Определите тактику ведения и лечения больной?
7.Показано ли оперативное лечение пациентки?
17. Дайте заключение следующей гемограмме:
Гемоглобин – 84 г/л, эр. – 2,8×*1012/л, ретикулоциты – 36‰; Тромбоциты 200×*109/л,
Лейкоциты – 8,9×*109/л, , Миел. –1, Метомиел. –1, П – 8, С – 70, Э – 1, Б – 1, Л–18 СОЭ - 31 мм/час.
57
III. 3 Апластическая анемия
Апластическая анемия – нозология, непосредственно связанная с костномозговой недостаточностью, и проявляющаяся снижением количества гемоглобина и эритроцитов с сохраненным уровнем их цветного показателя,
лейкопенией и тромбоцитопенией (рис. 14), с уменьшением клеточности костного мозга (рис. 15).
Среди причин этого состояния выделяют:
∙воздействие ряда лекарственных средств (антибиотики,
сульфаниламиды, цитостатики, НПВП, противотуберкулезные средства)
∙воздействие химических агентов (бензол, промышленные лаки,
краски, эмали)
∙ионизирующее излучение
∙беременность
∙перенесенный острый вирусный гепатит
Рисунок 14. Мазок крови при апластической анемии. Нормохромная гипорегенераторная анемия. Тромбоцитопения. Лейкопения.
58

Рисунок 15. Биоптат костного мозга при апластической анемии. Гипоклеточность. Замещение жировой тканью более, чем на 30%.
Несмотря на установленные этиологические факторы развития апластическая анемия, около половины случаев этого заболевания относится к идиопатическим формам, когда установление причин заболевания не представляется возможным.
Для определения тяжести апластической анемии разработаны особые критерии, так называемые «критерии Comitta»:
Сверхтяжелая апластическая анемия выставляется на основании снижения клеточности костного мозга до уровня не более 30 % от нормы и как минимум 2 следующих признака:
-уровень гранулоцитов менее 0,2*10\9 /л
-уровень тромбоцитов менее 20*10\9 /л
-уровень ретикулоцитов менее 1%
Тяжелая апластическая анемия включает в себя все признаки,
характерные для сверхтяжелой формы, однако уровень гранулоцитов здесь определяется как менее 0,5*10\9 /л
59